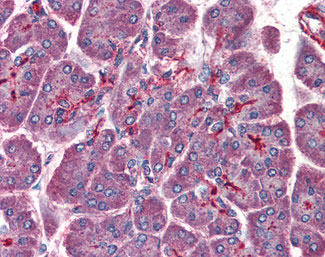

> Antigen, Antibodies, ELISA, Western Blot > Primary Antibody > Polyclonal Antibodies > PAFAH1B1 / LIS1 AntibodyBrand |
Leading Biology | Catalog Number |
APR12702G |
Product Type |
Polyclonal Antibodies | Field of Research |
|
Product Overview |
We constantly strive to ensure we provide our customers with the best antibodies. As a result of this work we offer this antibody in purified format.
We are in the process of updating our datasheets. If you have any questions regarding this update, please feel free to contact our technical support team.
This product is a high quality PAFAH1B1 / LIS1 antibody.
|
||
Molecular Weight |
47kDa
|
||
Cellular Localization |
Antigen Cellular Localization:
Cytoplasm, cytoskeleton. Cytoplasm, cytoskeleton, microtubule organizing center, centrosome Cytoplasm, cytoskeleton, spindle {ECO:0000255|HAMAP- Rule:MF_03141}. Nucleus membrane {ECO:0000255|HAMAP- Rule:MF_03141}. Note=Redistributes to axons during neuronal development. Also localizes to the microtubules of the manchette in elongating spermatids and to the meiotic spindle in spermatocytes (By similarity). Localizes to the plus end of microtubules and to the centrosome. May localize to the nuclear membrane.
|
||
Host |
Goat
|
||
Species Reactivity |
Human, Mouse, Rat, Rabbit, Zebrafish, Hamster, Monkey, Pig, Chicken, Horse, Xenopus, Bovine, Dog
|
||
Target |
Human PAFAH1B1 / LIS1.
|
||
GeneID |
|||
UniProt ID |
|||
Function |
Required for proper activation of Rho GTPases and actin polymerization at the leading edge of locomoting cerebellar neurons and postmigratory hippocampal neurons in response to calcium influx triggered via NMDA receptors. Non-catalytic subunit of an acetylhydrolase complex which inactivates platelet- activating factor (PAF) by removing the acetyl group at the SN-2 position (By similarity). Positively regulates the activity of the minus-end directed microtubule motor protein dynein. May enhance dynein-mediated microtubule sliding by targeting dynein to the microtubule plus end. Required for several dynein- and microtubule-dependent processes such as the maintenance of Golgi integrity, the peripheral transport of microtubule fragments and the coupling of the nucleus and centrosome. Required during brain development for the proliferation of neuronal precursors and the migration of newly formed neurons from the ventricular/subventricular zone toward the cortical plate. Neuronal migration involves a process called nucleokinesis, whereby migrating cells extend an anterior process into which the nucleus subsequently translocates. During nucleokinesis dynein at the nuclear surface may translocate the nucleus towards the centrosome by exerting force on centrosomal microtubules. May also play a role in other forms of cell locomotion including the migration of fibroblasts during wound healing.
|
||
Summary |
Required for proper activation of Rho GTPases and actin polymerization at the leading edge of locomoting cerebellar neurons and postmigratory hippocampal neurons in response to calcium influx triggered via NMDA receptors. Non-catalytic subunit of an acetylhydrolase complex which inactivates platelet- activating factor (PAF) by removing the acetyl group at the SN-2 position (By similarity). Positively regulates the activity of the minus-end directed microtubule motor protein dynein. May enhance dynein-mediated microtubule sliding by targeting dynein to the microtubule plus end. Required for several dynein- and microtubule-dependent processes such as the maintenance of Golgi integrity, the peripheral transport of microtubule fragments and the coupling of the nucleus and centrosome. Required during brain development for the proliferation of neuronal precursors and the migration of newly formed neurons from the ventricular/subventricular zone toward the cortical plate. Neuronal migration involves a process called nucleokinesis, whereby migrating cells extend an anterior process into which the nucleus subsequently translocates. During nucleokinesis dynein at the nuclear surface may translocate the nucleus towards the centrosome by exerting force on centrosomal microtubules. May also play a role in other forms of cell locomotion including the migration of fibroblasts during wound healing.
|
||
Form |
Liquid |
||
Storage & Stability |
Store at +4°C short term. For long-term storage, aliquot and store at -20°C or below. Stable for 12 months at -20°C. Avoid repeated freeze-thaw cycles.
|
||
Applications |
WB, IHC-P, E
|
||
Dilution |
ELISA (1:32000), IHC-P (3.75 μg/ml), WB (1-3 μg/ml)
|
||
Synonyms |
Platelet-activating factor acetylhydrolase IB subunit alpha {ECO:0000255|HAMAP-Rule:MF_03141}, Lissencephaly-1 protein {ECO:0000255|HAMAP-Rule:MF_03141}, LIS-1 {ECO:0000255|HAMAP-Rule:MF_03141}, PAF acetylhydrolase 45 kDa subunit {ECO:0000255|HAMAP-Rule:MF_03141}, PAF-AH 45 kDa subunit {ECO:0000255|HAMAP-Rule:MF_03141}, PAF-AH alpha {ECO:0000255|HAMAP-Rule:MF_03141}, PAFAH alpha {ECO:0000255|HAMAP-Rule:MF_03141}, PAFAH1B1 {ECO:0000255|HAMAP-Rule:MF_03141}
|
||
Images |
Anti-PAFAH1B1 / LIS1 antibody IHC of human pancreas. 
Anti-PAFAH1B1 / LIS1 antibody IHC of human thyroid. 
Anti-PAFAH1B1 / LIS1 antibody IHC of human brain, cortex. |
||
Specification |
|||
Quantity |
|
||
| Select | Brand | Catalog No. | Product Name | Pack Size | Type | Field of Research | Specification | Quantity | Price(USD) | |
| 1 | Leading Biology | APR03440G | ITGA11 Antibody (N-term) | 100 μl | Polyclonal Antibodies |
|
$495.00 | Add Ask | ||
| 2 | Leading Biology | APR04537G | CMIP Antibody (C-term) | 100 μl | Polyclonal Antibodies |
|
$495.00 | Add Ask | ||
| 3 | Leading Biology | APR12422G | Human H4 Histamine Receptor (extracellular) Antibody | 50 μl | Polyclonal Antibodies |
|
$695.00 | Add Ask | ||
| 4 | Leading Biology | APR03844G | UBE2W Antibody (C-term) | 100 μl | Polyclonal Antibodies |
|
$495.00 | Add Ask | ||
| 5 | Leading Biology | APR04349G | HECTD2 Antibody (N-term) | 100 μl | Polyclonal Antibodies |
|
$495.00 | Add Ask | ||
| 6 | Leading Biology | APR03502G | IGHG1 Antibody (Center) | 100 μl | Polyclonal Antibodies |
|
$495.00 | Add Ask |
 Leading Biology Inc.
2600 Hilltop DR, Building G, B Suite C138
Richmond, CA, 94806
Tel: 1-661-524(LBI)-0262
Email: info@leadingbiology.com
Leading Biology Inc.
2600 Hilltop DR, Building G, B Suite C138
Richmond, CA, 94806
Tel: 1-661-524(LBI)-0262
Email: info@leadingbiology.com
Complete this form and click send to ask us a question, request a quote or simply say hello.

You have 0 item in your cart

You have 0 item in your inquiry list
